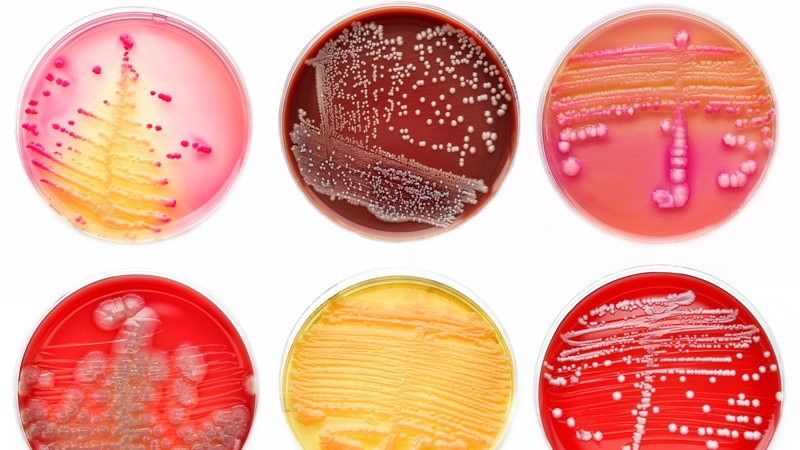

Research: knowing how bacteria sense their environment may be an Achilles heel that we can use to kill them
Bacteria are small cellular life forms that are extremely good at surviving all kinds of stresses. They have been around for much longer than us: there is good evidence that they have existed on earth for four billion years or so, whereas our ancestors appeared only in the last million years. They have had therefore plenty of time to adapt to the changeable conditions on our planet.
Like us, bacteria respond to stress by changing their behaviour. They can move away from the source of the stress or put up protective barriers to help them to survive. This ability to respond to stress is also present in bacterial pathogens that can infect us. When they get into our bodies, they are faced with stressful conditions (acid in the stomach for example) and they have to survive these before they can cause an infection. Once they sense that they are in a host, they protect themselves appropriately and they also switch on their virulence programme in order to begin the infection.
So how do the bacteria know where they are? How do they sense their environment so that they can behave appropriately? How do they know they are in a human host? Without this information, they wouldn’t be able to survive and importantly for us they wouldn’t be able to cause disease either!

PATHSENSE is an EU-funded project at the Department of Microbiology at NUI Galway which has begun to investigate this problem. The long term goal is to understand how bacteria sense their environment so that ultimately we can block this sensory system and prevent them from surviving in our food or in our bodies.
Imagine that you are deprived of all your senses (vision, hearing, smell, taste, touch) and then put into a dangerous situation, such as the middle of a busy motorway. Your chances of survival would be very small. If we could do the same to bacteria, we might be able to prevent them from surviving in situations where they pose a threat to us.
PATHSENSE is a €3.4 million project that involves eight different universities, a research institute and four companies spread across seven different EU countries. 13 researchers have been recruited who will move between laboratories for training and short research periods. While these researchers will tackle different aspects of how bacteria sense stress, all will be investigating a structure present in many bacteria that acts like a miniature brain for processing sensory information.
We need your consent to load this rte-player contentWe use rte-player to manage extra content that can set cookies on your device and collect data about your activity. Please review their details and accept them to load the content.Manage Preferences
From RTÉ Radio One's Countrywide, Ella McSweeney reports on how what happens on the farm matters when it comes to resistance to bacteria
The structure is called a "stressosome" because of the role it plays in allowing bacteria to sense stress. Although we know it exists we know very little about how it works. The stressosome is analogous to a brain and, like the human brain, we still have a huge amount to learn about how it works.
To understand how it gives a sensory capacity to bacteria, the PATHSENSE project will try to take this structure apart and work out what each sub-unit contributes to its function. The researchers will use a range of molecular tools to investigate its structure.
The long term goal is to understand how bacteria sense their environment so we can block this sensory system and prevent them from surviving in our food or bodies
A big challenge will be to work out how different stresses can be sensed by the same structure. As with human senses, bacteria can sense and respond to a range of different features in their environment, including changes in temperature, acidity and light. Information about each of these things can help the bacterium to "know" where it is and to respond accordingly. Inside a human, it’s dark and acidic and the temperature is a cosy 37˚C!
There are a number of food companies involved in the project, including the multinational giant Nestlé. For them the goal is to use the information we generate to help make food safer. If we could prevent bacterial pathogens from surviving in our food, a big improvement in food safety might be achievable. It might also help to extend the shelf life of food, which would be a big help to coping with global food shortages that are likely to increase as the human population continues to grow.